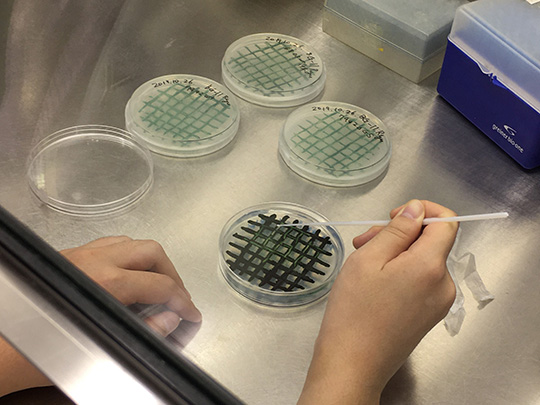

植物の物質生産や環境耐性などのしくみを分子レベルで解析し、
それらを制御・利用するバイオテクノロジー技術の確立を目指して
教育・研究を行います。
澱粉生合成メカニズムの解明と新規澱粉を生産するイネ品種の開発
私たちは、長年の澱粉研究の蓄積から、澱粉生合成メカニズムを解明すると同時に、新しい澱粉を蓄積する米品種を開発しています。ジャポニカ系高アミロース米「あきたぱらり」と「あきたさらり」、ジャポニカ系高レジスタントスターチ(RS)米の「A6」は、品種登録出願を済ませており、販売可能なステージまで来ています。
さらに詳しい説明はこちら。

糖質作用酵素の生化学・構造生物学
動物・微生物はグリコーゲンを、一方、植物は澱粉を生産します。これら多糖は複数の酵素によって作られますが、その詳しい仕組みはわかっていません。この仕組みを解き明かすため、私たちは糖質の代謝に関わる酵素の性質と立体構造を調べる研究をしています。研究成果をプラスチックの代替となる新規澱粉素材の酵素合成などへ利用することを目指しています。
さらに詳しい説明はこちら。

シアノバクテリアにおける炭水化物代謝の解析
シアノバクテリアは葉緑体の起源と考えられている原始的な光合成微生物です。大部分の種はグリコーゲンを貯めますが、ごく一部の種は植物の澱粉に似た“進化型の”多糖を生産します。また高塩濃度環境においては蔗糖(スクロース)など比較的低分子の炭水化物を蓄積します。シアノバクテリアにおける炭水化物代謝機構の解析を通じて、光合成生物の生存戦略の普遍性に迫ります。
さらに詳しい説明はこちら。